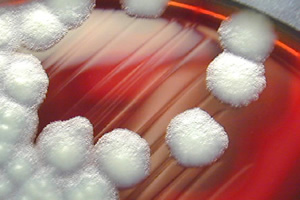

Bacillus cereus es una causa importante de toxiinfecciones alimentarias en las personas. Esta bacteria es formadora de toxinas termoestables, como la toxina emética cereulida, que una vez ingerida en alimentos contaminados por ella provoca nauseas y vómitos. Una nueva norma UNE, publicada recientemente por AENOR, describe el análisis cuantitativo de la toxina emética cereulida, aplicable en productos destinados al consumo humano.
La toxina emética cereulida
Bacillus cereus es un patógeno ubicuo en el medioambiente, por lo que podemos hallarlo en una gran variedad de materias primas y alimentos de origen agrícola y ganadero.
Bacillus cereus es un patógeno ubicuo en el medioambiente, por lo que podemos hallarlo en una gran variedad de materias primas y alimentos de origen agrícola y ganadero.
Aunque las concentraciones de Bacillus cereus presentes en dichos alimentos son bajas para producir toxiinfecciones alimentarias, su habilidad para formar esporas hace posible que sobreviva a lo largo del procesado del alimento, y una posterior conservación inadecuada del mismo, excediendo temperatura y tiempo, potencia su multiplicación a niveles que producen toxiinfecciones.
Los brotes de Bacillus cereus ocurridos en Europa en los últimos años se asocian a una gran variedad de alimentos: platos preparados de carnes, pescados y vegetales (albóndigas, estofados, puddings, etc) y con arroz, pasta y patata, cremas, sopas, leche y derivados lácteos (queso, natillas, flanes, etc.)
Entre los diversos tipos de toxinas que puede producir Bacillus cereus, se encuentra la cereulida (toxina emética), que es termoestable y no puede destruirse con tratamientos térmicos estandar. La producción de la toxina ocurre durante la fase estacionaria del crecimiento del microorganismo, y se acumula en el alimento a medida que transcurre el tiempo. La intoxicación emética, debida a la ingesta de la toxina formada en el alimento, se caracteriza por náuseas agudas y vómitos.
UNE-EN ISO 18465, en busca de la toxina emética
AENOR acaba de publicar la nueva Norma UNE-EN ISO 18465 (adopta la ISO 18465:2017) sobre el análisis cuantitativo de la toxina emética (cereulide) utilizando LC-MS/MS.
La norma ha sido elaborada por el comité técnico CTN 34 Productos alimentarios, cuya secretaría desempeña la Federación Española de Industrias de Alimentación y Bebidas (FIAB).
En este documento se describe el análisis cuantitativo de la toxina emética cereulida mediante el uso de cromatografía líquida de alto rendimiento (HPLC; high performance liquid chromatography) o cromatografía líquida de ultra-alto rendimiento (UHPLC; ultra performance liquid chromatography) conectadas en tándem a un espectrómetro de masas (LC-MS/MS).
La norma puede aplicarse al análisis de la toxina en productos destinados al consumo humano.
Contenido de la norma
- 0 Introducción
- Objeto y campo de aplicación
- 2 Normas para consulta
- Términos y definiciones
- Principio general
- Reactivos
- Aparatos y equipamiento
- Procedimiento
Preparación de las muestras
Preparación de los patrones
Análisis mediante LC-MS
Condiciones de LC
Condiciones de MS y ajuste de parámetros
Transiciones (seguimiento de múltiples reacciones, MRM) - 8 Cálculos
- 9 Controles de calidad
- Precisión
Generalidades
Repetibilidad
Reproducibilidad - Anexo A (Informativo) Resultados del estudio interlaboratorios
- Anexo B (Informativo) Transiciones posibles de cereulida en MS
- Bibliografía
Imagen: CDC








